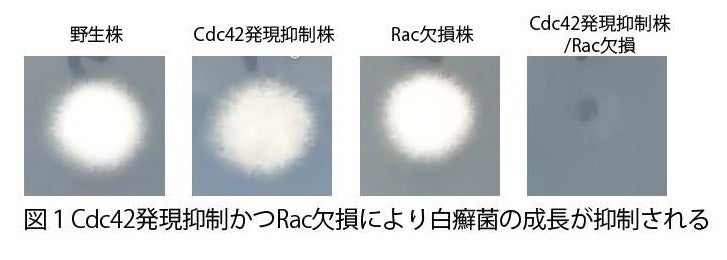

【武蔵野大学・明治薬科大学・帝京大学 共同プレスリリース】白癬菌の爪における増殖を抑制する新たな分子標的を発見
本研究は、白癬菌に対する新たな治療薬の発見に繋がるものと期待されます。
本研究成果は、国際連合が定めた「持続可能な開発目標(SDGs)」のうち、「3.すべての人に健康と福祉を」に貢献するものです。
図:本研究のイメージ
【本研究成果のポイント】
白癬菌の低分子量Gタンパク質Cdc42及びRacの菌糸成長における必要性を解明
真菌Cdc42及びRac阻害剤による、爪における白癬菌の増殖抑制効果を発見
【本研究の背景】
白癬(水虫)は、国民病とも言われ、日本人の足(あし)白癬(はくせん)の罹患率は21.6%と推計されており*1、日本の人口が1億2000万人であることから、罹患者数は2500万人以上に上ると推測されます。水虫を含む真菌(カビなど)による感染症の治療薬はその数が限られており、新たな治療標的の発見とそれを標的とした薬剤開発が求められています。
【研究の内容と結果】
(1)白癬菌の低分子量Gタンパク質Cdc42及びRacの菌糸成長における必要性を解明
白癬菌の成長に必要な分子を探索するため、生物一般の細胞機能制御に必須のタンパク質である低分子量Gタンパク質に着目して研究を進め、事前の検討によりGタンパク質Cdc42及びRacが菌糸成長を促進することが示唆されました。
そこで、遺伝子組換え技術を用いて、Cdc42の発現量の抑制に加えてRacを欠損させたところ、野生株(遺伝子組換えをしていない元の菌株)と比べて、顕著に培地*2上での成長が抑制されることが分かりました(図1)。
Gタンパク質はその名にGとあるとおり、核酸のRNAを合成する基質である“G”TPと、そこからリン酸基が一つとれた“G”DPと結合します。GTPに結合すると細胞内シグナルをONに、GDPと結合すると細胞内シグナルをOFFにする細胞内シグナルのスイッチとして機能しており、このスイッチを切り替えることで、例えば増殖のONとOFFが切り替わります。

このONとOFFのスイッチの切り替えを担うタンパク質がGuanine nucleotide exchange factor (GEF)です。タンパク質のアミノ酸配列情報を基に白癬菌Cdc42及びRacのGEF(Cdc24)を特定し、その発現を抑制すると、菌糸成長が顕著に抑制されるとともに、細胞の形態や細胞の骨格タンパク質アクチンの局在に異常をきたし、死細胞が増加することが明らかになりました(図2)。
(2)真菌のCdc42及びRacの機能を阻害する化合物が爪における白癬菌の増殖を抑制することを発見
化合物を用いて白癬菌Cdc42及びRacの機能を阻害することを目的に、哺乳類のCdc42もしくはRacを阻害することが知られる薬の中から白癬菌Cdc42及びRacを阻害可能な化合物を探索しました。

その結果、低分子化合物EHop-016が白癬菌Cdc42及びRacを試験管内で阻害し、培地での白癬菌の増殖も抑制することを見出しました。さらに、白癬菌の胞子懸濁液を爪の上に塗布し、EHop-016をさらに塗布した爪では、白癬菌の増殖が抑制されることを見出しました(図3)。以上のことから、Cdc42及びRacが白癬菌の増殖を促進すること、そしてその阻害剤を用いることで白癬菌の増殖を抑制できることが示唆されました。本研究成果により、新たな治療薬の発見に繋がるものと期待されます。
【研究支援】
本研究は、以下の助成を受けて行われました。
・日本学術振興会 科学研究費助成事業 若手研究(19K16656、21K15438、代表:石井 雅樹)
・日本学術振興会 科学研究費助成事業科研費 基盤研究(C) (23K06533、代表:石井 雅樹)
・日本学術振興会 科学研究費助成事業科研費 基盤研究(B) (17H03981、代表:堅田 利明)
・日本学術振興会 科学研究費助成事業科研費 基盤研究(C) (20K06550、代表:堅田 利明)
・日本学術振興会 科学研究費助成事業科研費 若手研究(A) (16H06163、代表:大畑 慎也)
・武田科学振興財団 薬学系研究助成(代表:大畑 慎也)
・武蔵野大学 大学研究費(代表:大畑 慎也)
【論文タイトルと著者】

タイトル | Targeting dermatophyte Cdc42 and Rac GTPase signaling to hinder hyphal elongation and virulence |
著者 | Masaki Ishii, Yasuhiko Matsumoto, Tsuyoshi Yamada, Hideko Uga, Toshiaki Katada, Shinya Ohata. |
掲載紙 | iScience DOI: https://doi.org/10.1016/j.isci.2024.110139 |
【出典・用語解説】
*1 日本皮膚科学会皮膚真菌症診療ガイドライン 2019
*2 培地:細胞や微生物が成長しやすいよう人工的に作られた環境のこと。
【関連リンク】
■武蔵野大学薬学部薬学科:
https://www.musashino-u.ac.jp/academics/faculty/pharmacy
■帝京大学医真菌研究センター:
https://www.teikyo-u.ac.jp/affiliate/laboratory/timm
■iScience(本研究成果掲載紙):
https://www.cell.com/iscience/home
【問合せ先】
■武蔵野大学 薬学部薬学科 准教授 大畑 慎也、講師 石井 雅樹
TEL:042-468-8664
E-mail:m_ishii@musashino-u.ac.jp
■武蔵野大学 経営企画部 広報課(担当:谷内田・右原)
TEL:03-5530-7403
E-mail:kouhou@musashino-u.ac.jp
■明治薬科大学 広報課(担当:高橋)
TEL:042-495-8615(直通)
E-mail:koho@my-pharm.ac.jp
■帝京大学 本部広報課(担当:守川)
TEL:03-3964-4162
E-mail:kouhou@teikyo-u.ac.jp
このプレスリリースには、メディア関係者向けの情報があります
メディアユーザー登録を行うと、企業担当者の連絡先や、イベント・記者会見の情報など様々な特記情報を閲覧できます。※内容はプレスリリースにより異なります。
すべての画像
